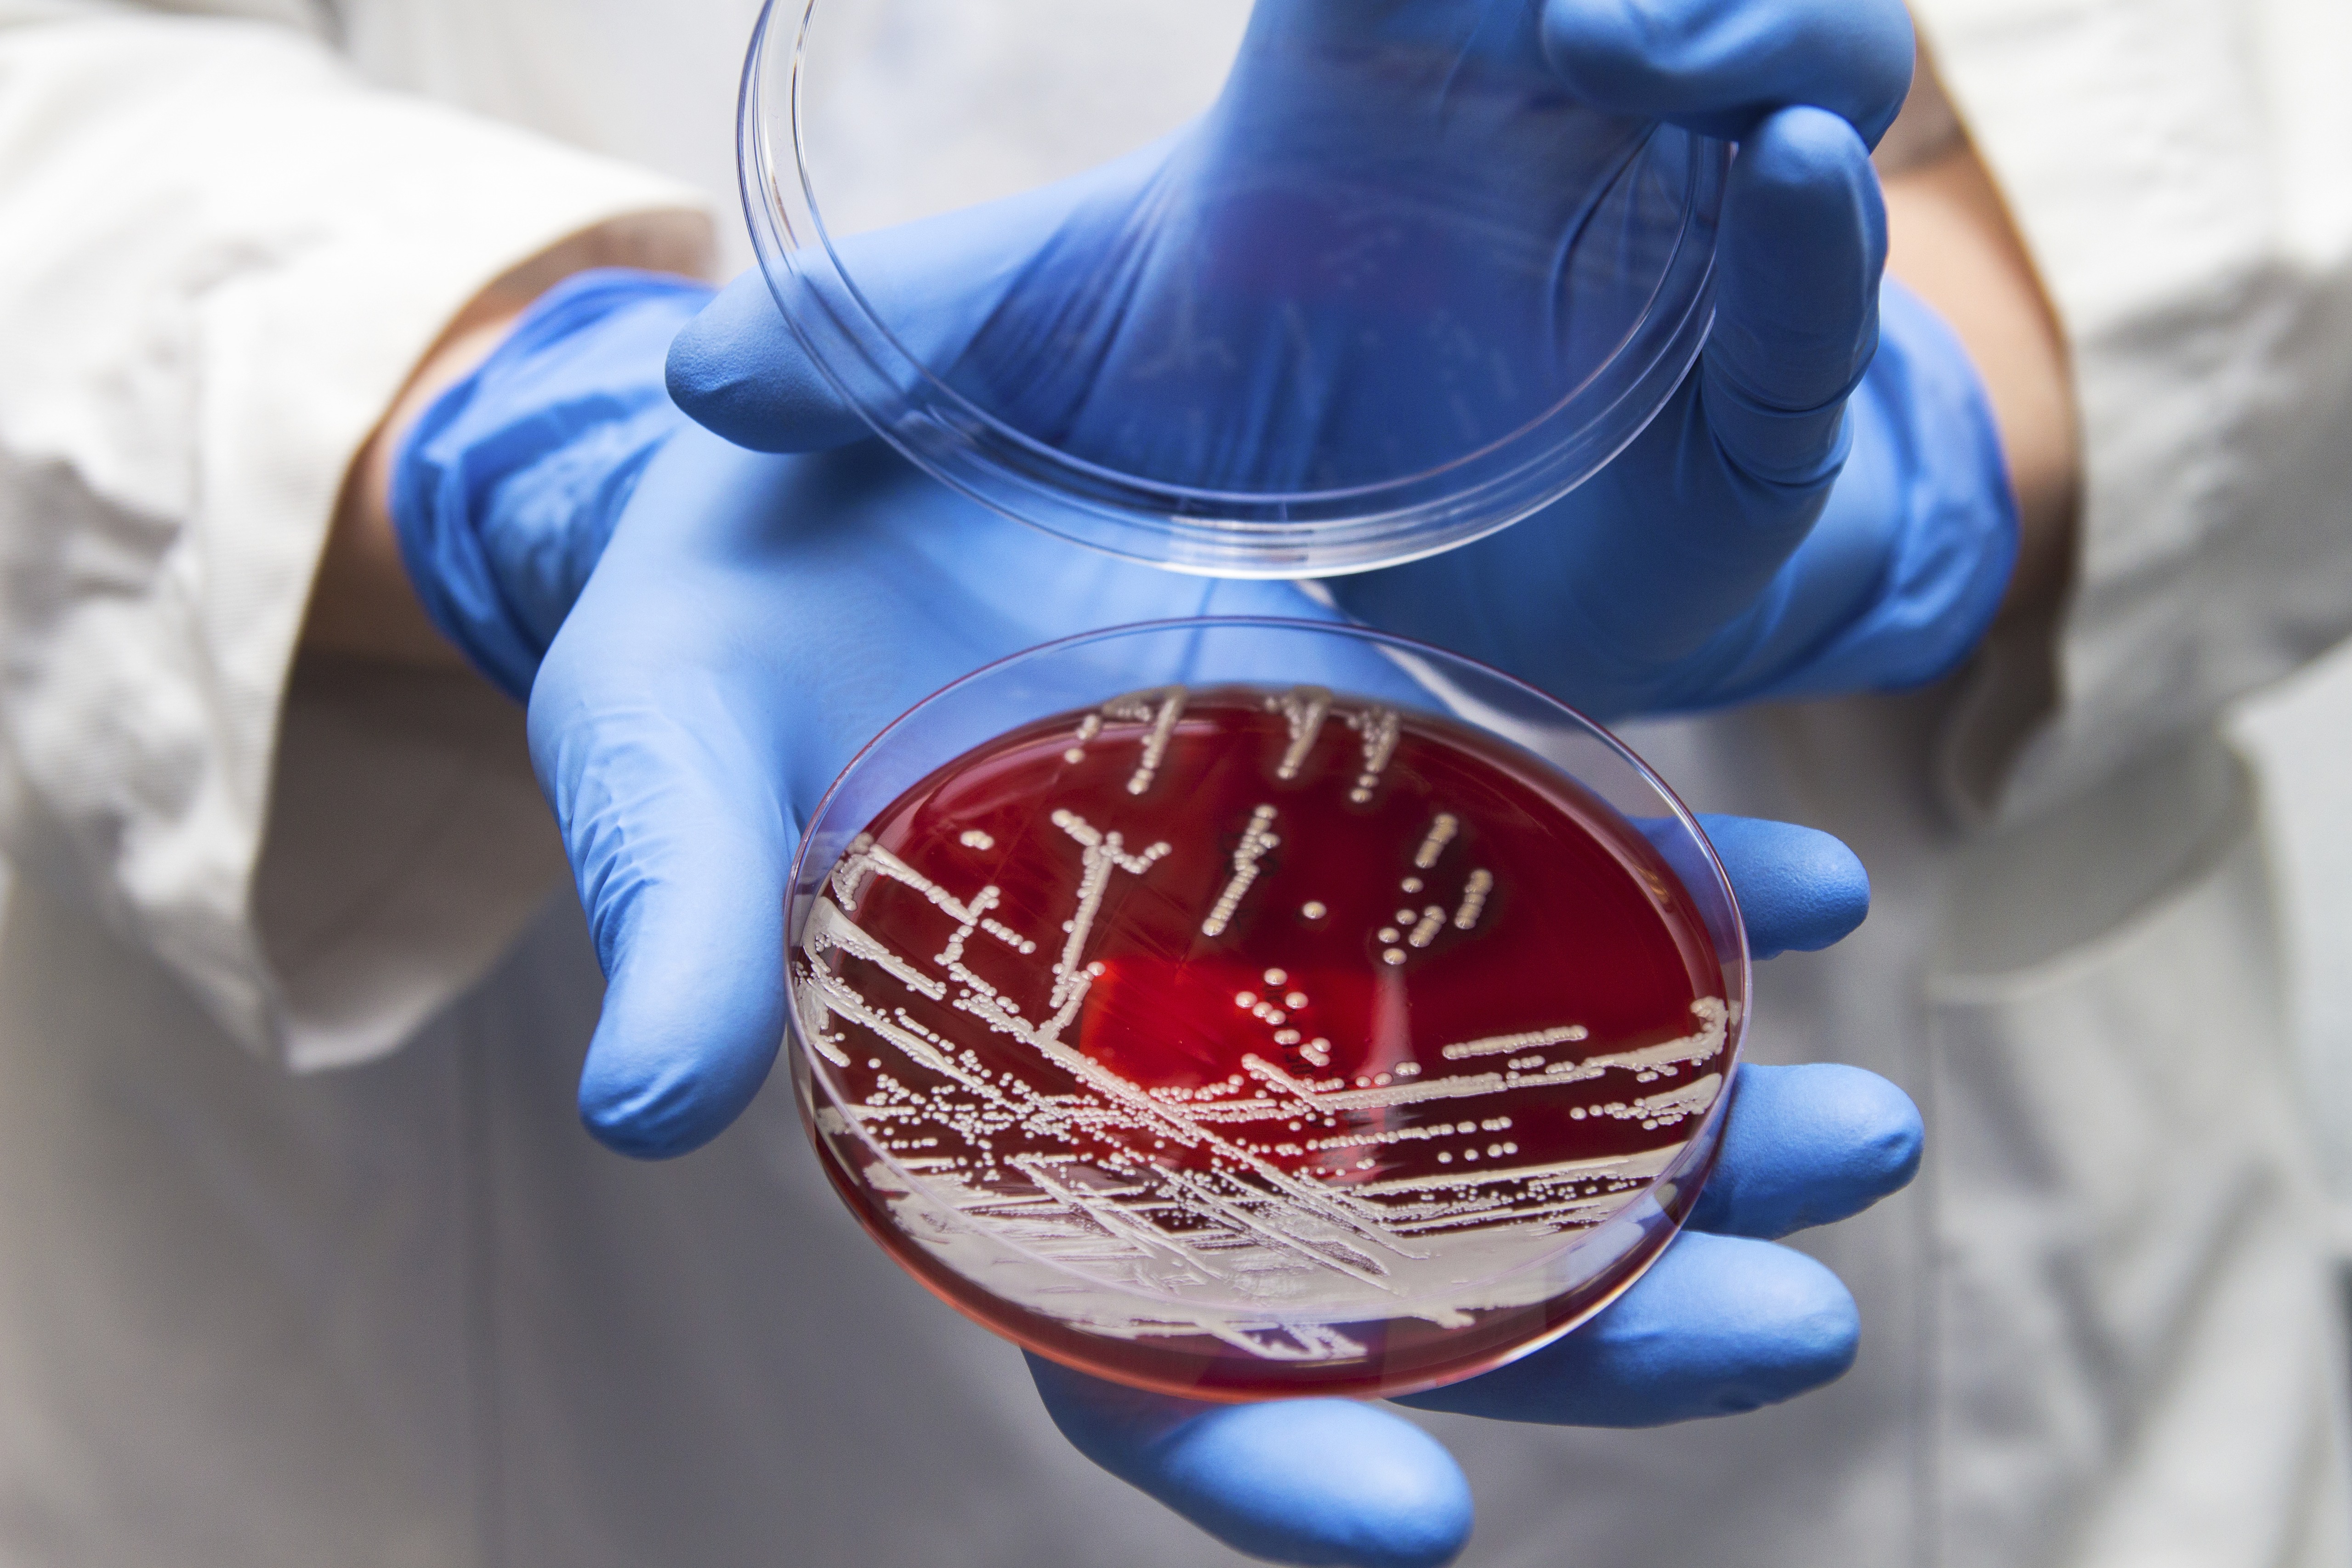

|
| ´þ°í ½Àµµ ³ôÀº ¿©¸§Ã¶, ½ÄÁßµ¶ ºñ»ó°æº¸! |
 |
|
| ±Û¾´ÀÌ : ÃÖ°í°ü¸®ÀÚ
³¯Â¥ : 25-08-27 14:58
Á¶È¸ : 225
Æ®·¢¹é ÁÖ¼Ò |
|
https://blog.naver.com/h8758887/223985256694 (87) |
|
¾È³çÇϼ¼¿ä.
"È¿¿Í Á¤¼ºÀ» °¡µæ ´õÇÑ ³ëÀÎÄɾî, È¿´õÇÔ ³ëÀκ¹Áö¼¾ÅÍÀÔ´Ï´Ù."
¿Âµµ¿Í ½Àµµ°¡ ³ôÀº ¿©¸§Ã¶Àº °¢Á¾ ¼¼±ÕÀÌ ¹ø½ÄÇϱ⠽¬¿î ȯ°æÀÌ´Ù. ¶§¹®¿¡ ±×·Î ÀÎÇÑ Áúº´µµ ÈçÇÏ°Ô ¹ß»ýÇϴµ¥, ƯÈ÷ À帶ö¿¡´Â ½ÄÁßµ¶¿¡ ´ëÇÑ ÁÖÀǰ¡ ÇÊ¿äÇÏ´Ù. ½ÇÁ¦·Î ½ÄǰÀǾàǰ¾ÈÀüó ÀÚ·á¿¡ µû¸£¸é ÃÖ±Ù 3³â °£ ¹ß»ýÇÑ ½ÄÁßµ¶ ¾à 35.2%°¡ ¿©¸§Ã¶¿¡ ¹ß»ýÇß´Ù.
½ÄÁßµ¶ ¿øÀÎ ´ëºÎºÐÀÌ À½½Ä¹° ¼·Ãë·Î ÀÎÇÑ °ÍÀÎ ¸¸Å »ýȰ ¼Ó¿¡¼ ÁÖÀÇÇÒ Á¡, ±×¸®°í °ü¸® ¹æ¹ý µî¿¡ ´ëÇØ ¾Ë¾Æº¸ÀÚ.
´ëºÎºÐ À½½Ä¹° ¼·Ãë·Î ¹ß»ýµÇ´Â ½ÄÁßµ¶
½ÄÁßµ¶Àº À½½Ä¹° ¼·Ãë·Î ¼ÒȱⰡ °¨¿°µÇ¾î ¹èÅ», ¼³»ç, º¹Åë µîÀÇ Áõ»óÀÌ ±Þ¼º ¶Ç´Â ¸¸¼ºÀ¸·Î ³ªÅ¸³ª´Â ÁúȯÀÌ´Ù. ¼¼°èº¸°Ç±â±¸(WHO)¿¡¼´Â ½ÄÁßµ¶À»'½Äǰ ¶Ç´Â ¹°ÀÇ ¼·Ãë¿¡ ÀÇÇØ ¹ß»ýµÇ¾ú°Å³ª ¹ß»ýµÈ °ÍÀ¸·Î »ý°¢µÇ´Â °¨¿°¼º ¶Ç´Â µ¶¼ÒÇü Áúȯ"À¸·Î ±ÔÁ¤Çϰí ÀÖ´Ù.
ÀÌó·³ ´ëºÎºÐ À½½Ä¹° ¼·Ãë·Î ¹ß»ýµÇ¾î ½Äǰ¸Å°³ÁúȯÀ̶ó°í ÇÏ´Â °ÍÀÌ Á¤È®ÇÑ ¸íĪÀÌ´Ù.
½ÄÁßµ¶ÀÇ À¯ÇüÀº ¿øÀÎ ¹°Áú¿¡ µû¶ó ºÐ·ùÇÒ ¼ö ÀÖ´Ù.
¨ç ½Äǰ ¾È¿¡ ÀÖ´Â ¹Ì»ý¹°ÀÌ »ý»êÇÏ´Â µ¶¼Ò¿¡ ÀÇÇÑ ½ÄÁßµ¶
¨è º¹¾î³ª ¸ð½ÃÁ¶°³ µîÀÇ µ¿¹°¼º µ¶¼Ò
¨é ¹ö¼¸, °¨ÀÚ µîÀÇ ½Ä¹°¼º µ¶¼Ò¿¡ ÀÇÇÑ ÀÚ¿¬µ¶ ½ÄÁßµ¶
¨ê ÈÇÐ ¹°Áú¿¡ ÀÇÇÑ ÈÇмº ½ÄÁßµ¶
¨ë ¼¼±Õ¿¡ ÀÇÇÑ ¼¼±Õ¼º ½ÄÁßµ¶
ÀÌ Áß ¼¼±Õ¼º ½ÄÁßµ¶À» À¯¹ßÇÏ´Â ¼¼±ÕÀº ÀåÆ¼Çª½º¸¦ ÀÏÀ¸Å°´Â »ì¸ð³Ú¶ó±Õ, ÀÌÁú±Õ, Àå¿°ºñºê¸®¿À±Õ µîÀÌ ÀÖ´Ù.
µ¶¼Ò ¹èÃâÀ» À§ÇØ ³ªÅ¸³ª´Â ±¸Åä¿Í ¼³»ç
°¡Àå ÈçÇÏ°Ô ³ªÅ¸³ª´Â Áõ»óÀº ±¸Åä, ¼³»ç, º¹Åë µîÀÌ´Ù. ü³»¿¡ µ¶¼Ò°¡ µé¾î¿ÔÀ» ¶§ À̸¦ Á¦°ÅÇϱâ À§ÇØ ¿ì¸® ¸öÀÌ ¹ÝÀÀÇÏ´Â °Í. ±¸Åä´Â À§Àå ³» µ¶¼Ò¸¦ ¸ö ¹ÛÀ¸·Î ¹èÃâÇϱâ À§ÇØ, ¼³»ç´Â Àå³» µ¶¼Ò¸¦ ¾Ä¾î³»±â À§ÇØ ³ªÅ¸³ª´Â ¹ÝÀÀÀÌ´Ù. ¶§¹®¿¡ ÀÇ»ç¿ÍÀÇ »óÀÇ ¾øÀÌ ÇԺηΠÁö»çÁ¦¸¦ »ç¿ëÇÒ °æ¿ì µ¶¼Ò³ª ¼¼±Õ ¹èÃâÀ» Áöü½ÃÄÑ ¿ÀÈ÷·Á ȸº¹ÀÌ ´Ê¾îÁú ¼ö ÀÖ´Ù. ÀÌ ¿Ü¿¡µµ ÀϺΠ¼¼±ÕÀº ü³»¿¡¼ µ¶¼Ò¸¦ ¸¸µé¾î³» ½Å°æ ¸¶ºñ, ±ÙÀ° °æ·Ã, ÀÇ½Ä Àå¾Ö µîÀ» À¯¹ßÇϱ⵵ ÇÑ´Ù.
ÀÌ °æ¿ì ¼³»ç¿Í ±¸Åä·Î ÀÇÇÑ Å»¼ö Ä¡·á¸¦ À§ÇØ °æ±¸³ª Á¤¸ÆÁֻ縦 ÅëÇØ ÃæºÐÇÑ ¼öºÐÀ» °ø±ÞÇØ¾ß ÇÑ´Ù. ´ëºÎºÐÀÇ ½ÄÁßµ¶ Áõ»óÀº ÀÌ °°Àº ´ëÁõ¿ä¹ý¸¸À¸·Îµµ ¼öÀÏ ³»¿¡ ȸº¹µÇÁö¸¸ ½É°¢ÇÑ »óÅÂÀÇ Áõ»óÀÌ Áö¼ÓµÇ°Å³ª 38¡ÉÀÌ»óÀÇ ¹ß¿, Çǰ¡ ¼¯ÀÎ ¼³»ç µîÀÌ ÀÖ´Ù¸é Àü¹®ÀÇÀÇ Áø·á°¡ ÇÊ¿äÇÏ´Ù. ½±°Ô Å»¼ö°¡ µÇ´Â ¿µ¡¤À¯¾Æ¿Í ³ëÀÎ ¿ª½Ã ºü¸£°Ô º´¿øÀ» ¹æ¹®ÇØ Ä¡·á¸¦ ¹Þ´Â °ÍÀÌ ¾ÈÀüÇÏ´Ù.
ÃæºÐÇÑ ¼öºÐ ¼·Ãë¿Í ¿µ¾ç º¸Ãæ ÇÊ¿ä
½ÄÁßµ¶À¸·Î ¼³»ç, ±¸Åä µîÀ» ÇÏ´Ù º¸¸é ü³» ¼öºÐ ¹× ÀüÇØÁú, ¿µ¾çºÐ µîÀÇ ºÒ±ÕÇüÀÌ ÀϾ ¼ö ÀÖ´Ù. ÇÏÁö¸¸ À§Àå ±â´ÉÀÌ ¶³¾îÁø »óÅÂÀ̹ǷΠ¹ßº´ ÈÄ 24½Ã°£ µ¿¾ÈÀº ±Ý½ÄÇÏ´Â °ÍÀÌ ÁÁ´Ù. À§Àå ±â´ÉÀÌ È¸º¹µÈ ÈÄ¿¡´Â À¯µ¿½ÄÀ¸·Î ½ÃÀÛÇØ °í´Ü¹é ¿µ¾çÀ½·á, ºÎµå·¯¿î Á× µîÀ» ¼·ÃëÇ쵂 ÀûÀº ¾çÀ» ÀÚÁÖ ¼·ÃëÇϱ⸦ ±ÇÀåÇÑ´Ù. ´Ü, ¸¼Àº À¯µ¿½Ä¸¸À¸·Î´Â ¿µ¾ç¼Ò°¡ ºÎÁ·ÇÒ ¼ö ÀÖÀ¸¹Ç·Î ÀÌÆ² ÀÌ»ó ¼·ÃëÇÏÁö ¾Êµµ·Ï ÇÑ´Ù.
±ÕÇü ÀâÈù ¿µ¾ç ¼·Ã븦 À§ÇØ ºÎµå·¯¿î À°·ù, »ý¼±, µÎºÎ, °è¶õ µîÀÌ µµ¿òÀÌ µÈ´Ù.
ÇÏÁö¸¸ ±â¸§Áø À°·ù, À¯Á¦Ç°, °ß°ú·ù, Æ¢±è µîÀº »ï°¡´Â °ÍÀÌ ÁÁ´Ù. ÀϹÝÀûÀ¸·Î °Ç°¿¡ ÀÌ·Ó´Ù°í ¿©°ÜÁö´Â »ý°úÀÏ, »ýä¼Ò, Àâ°î¹äµµ ½ÄÁßµ¶ ȯÀÚ¿¡°Ô´Â ÇÇÇØ¾ß ÇÒ À½½ÄÀÌ´Ù. ¼ÒÈ ´É·ÂÀÌ ÀúÇÏµÈ »óÅÂÀ̹ǷΠ»ý°úÀÏÀ̳ª ä¼Òº¸´Ù´Â ÁÖ½º ÇüŰ¡ ÀûÇÕÇϸç, Àâ°îº¸´Ù´Â ºÎµå·¯¿î ½Ò¹äÀÌ ³´´Ù.
À½½ÄÀº ³ÃÀå º¸°üÇÏ°í °³ÀÎÀ§»ý öÀúÈ÷
À½½ÄÀ» ¸¸µé°í ¸ÔÀ» ¶§ ¼Õ ½Ë±â´Â ½ÄÁßµ¶ ¿¹¹æÀÇ ±âº»ÀÌ´Ù. ½Äǰ Á¶¸®¿¡ »ç¿ëÇÏ´Â ±â±¸ ¿ª½Ã Ç×»ó ±ú²ýÇÏ°Ô ¼¼Ã´Çϰí ÁÖ±âÀûÀ¸·Î ¼Òµ¶ÇØ¾ß ÇÑ´Ù. ƯÈ÷ Ä®°ú µµ¸¶´Â ±³Â÷ ¿À¿°ÀÌ ¹ß»ýÇÏÁö ¾Êµµ·Ï À°·ù, ¾îÆÐ·ù, °úÀÏ¿ë µîÀ¸·Î ±¸ºÐÇØ »ç¿ëÇÏ´Â °ÍÀÌ ¾ÈÀüÇÏ´Ù.
¿©¸§Ã¶¿¡´Â ±â¿ÂÀÌ ³ôÀº ¸¸Å Á¶¸®ÇÑ À½½ÄÀº ¹Ù·Î ¸Ô°í, ³²Àº À½½ÄÀº ¹Ù·Î ³ÃÀå º¸°ü ÇØ¾ß ÇÑ´Ù.
³ÃÀå º¸°üÇÑ À½½ÄÀ» ¸ÔÀ» ¶§µµ Àç°¡¿Çϱ⸦ ±ÇÀåÇÑ´Ù. ¶ÇÇÑ ³Ãµ¿µÈ Á¦Ç° ÇØµ¿Àº ³ÃÀå½Ç ȤÀº ÀüÀÚ·¹ÀÎÁö¸¦ »ç¿ëÇϰí, »ýÀ¸·Î ¸Ô´Â °úÀϰú ¾ßä´Â Àü¿ë ¼¼Á¦¸¦ »ç¿ëÇØ ²Ä²ÄÇÏ°Ô ¼¼Ã´ÇØ¾ß ÇÑ´Ù.
*Âü°í : ¼¿ï¾Æ»êº´¿ø, Áúº´°ü¸®Ã»
Ãâó:±¹¹Î°Ç°º¸Çè°ø´Ü ºí·Î±×
(ÁÖ)¸ðÇǾ¿¥ È¿´õÇÔ
|
|